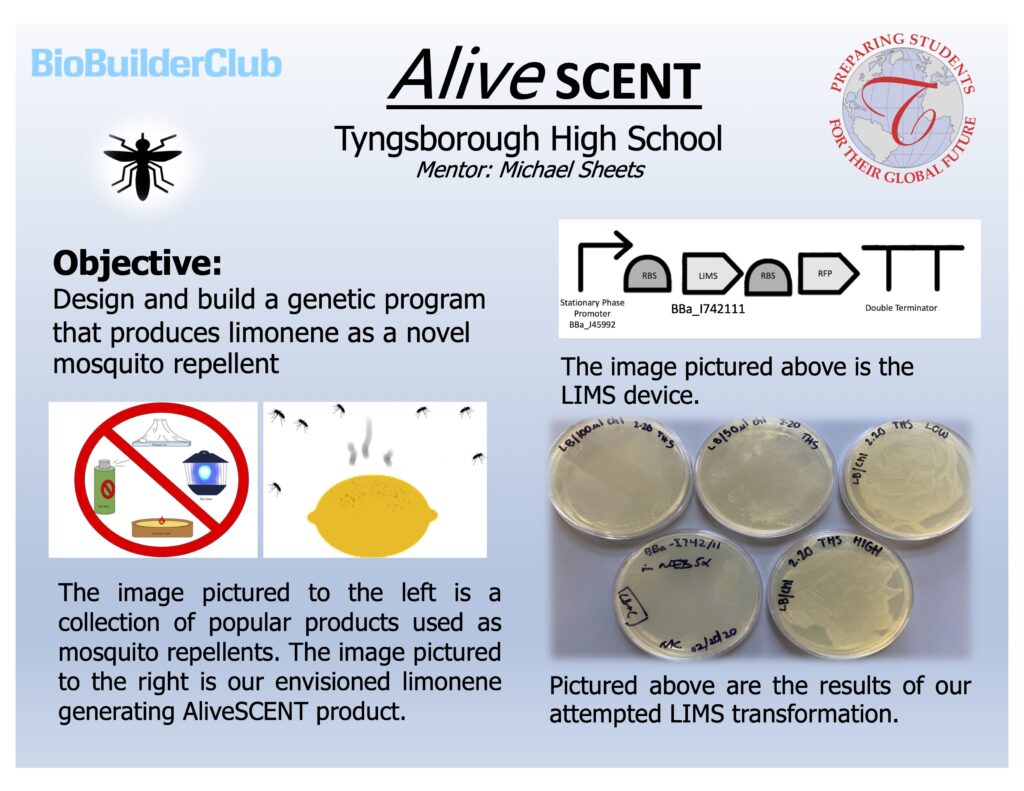

We designed and began to build a genetic program that produces limonene as a novel mosquito repellent

We designed and began to build a genetic program that produces limonene as a novel mosquito repellent
School
Tyngsborough HS
Tyngsborough, MA
BioBuilderClub Season
2019-2020 Season
Category
Resources